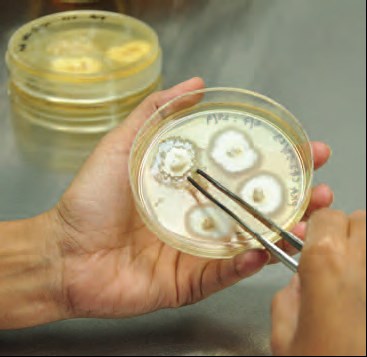

IsDB 50th Anniversary
As part of the 50th anniversary commemorations of the Islamic Development Bank, a special Ramadan Iftar will be organized on 23 February 2026, coinciding with the launch of the 50th Anniversary Documentary film that highlights the historic and strategic relationship between the Kingdom of Saudi Arabia and the establishment of the IsDB. The event also coincides with the Founding Day of the Kingdom of Saudi Arabia, underscoring the IsDB Group’s deep appreciation of the Kingdom’s pivotal role in the creation and continued support of the IsDB Group since its inception. This occasion will convene dignitaries, ministers from the Kingdom of Saudi Arabia, former Presidents of the IsDB, 2026 IsDB Group Board of Governors Chairman, members of the Group’s Boards, and other eminent guests who have played a significant role in strengthening the partnership between the IsDB Group and the Kingdom of Saudi Arabia, together with all IsDB Group staff members in HQ.